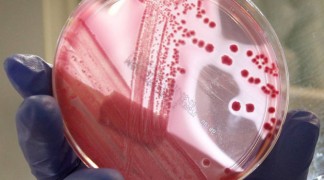
Przygotowanie do badań

Badanie krwi
- Na pobranie krwi należy zgłosić się na czczo, najlepiej rano w godzinach 6:30-12:00
- zaleca się aby wieczorem dnia poprzedzającego badanie zjeść lekkostrawną kolację
- przed pobraniem krwi pacjent powinien odpocząć przez około 10 minut
- w przypadku badań hormonów płciowych należy ustalić dzień cyklu zgodnie z zaleceniem lekarza
- w przypadku badania "krzywa cukrowa" pacjent przebywa w laboratorium 2 godziny. W tym czasie nie powinien spożywać żadnych pokarmów.
Wymaz z gardła lub migdałków podniebiennych
Do laboratorium należy zgłosić się rano, na czczo, przed wykonaniem toalety jamy ustnej (przed myciem zębów), po przepłukaniu jamy ustnej świeżo przegotowaną wodą. Jeśli jest to możliwe, przed pobraniem wymazu nie należy spożywać żadnych posiłków ani napojów przynajmniej przez 3 godziny.
Picie i jedzenie może mechanicznie „usunąć” obecne na błonach śluzowych drobnoustroje chorobotwórcze.
Wymaz z nosa, oka, ucha, skóry, ran
Badanie wymazu z nosa, oka, ucha, skóry czy rany nie wymaga w zasadzie żadnych szczególnych przygotowań ze strony Pacjenta. Należy jednak pamiętać, aby przed pobraniem wymazu nie stosować żadnych kropli czy maści, szczególnie zawierających antybiotyk lub bakteriostatyk , gdyż mogą one znacznie zafałszować wynik badania.
Wymazy z dróg moczowo-płciowych
Laboratorium przyjmuje wymazy pobrane w specjalistycznych gabinetach ginekologicznych na podłożu transportowym.
Przed pobraniem wymazu należy wykonać toaletę narządów moczowo-płciowych (mycie wodą z mydłem lub płynem do higieny intymnej, ale nie bakteriobójczym). Przed planowanym badaniem nie powinno się stosować żadnych maści, globulek dopochwowych, żeli plemnikobójczych itp. Wskazane również jest zachowanie wstrzemięźliwości seksualnej na dobę przed badaniem.
Na pobranie do gabinetu ginekologicznego należy zgłosić się po przynajmniej 3 godzinnej przerwie po ostatnim oddaniu moczu , gdyż przepływający mocz może spłukać bytujące w narządach moczowo-płciowych nabłonki oraz bakterie chorobotwórcze i nie będzie możliwe ich wyhodowanie pomimo toczącej się infekcji.
Plwocina
Plwocinę należy odkrztusić rano, na czczo, do jałowego pojemniczka (sterylny do posiewu moczu dostępny w każdej aptece) po wykonaniu toalety jamy ustnej (umyciu zębów) i przepłukaniu jamy ustnej świeżo przegotowaną wodą.
Nie można dotykać wewnętrznych powierzchni pojemnika. Materiał należy dostarczyć do laboratorium w jak najkrótszym czasie.
Mocz
U dorosłych i dzieci (nie używających już pieluszek) do badania mikrobiologicznego najlepiej nadaje się środkowy strumień porannego moczu. Mocz należy oddać do jałowego pojemnika (dostępny w każdej aptece) po uprzednim dokładnym, trzykrotnym podmyciu wodą z mydłem lub wodą przegotowaną (u mężczyzn dodatkowo po odciągnięciu napletka i dokładnym zmyciu wydzieliny spod napletka), bez wycierania ręcznikiem. Nie używamy ręcznika, ponieważ może on być dodatkowym źródłem bakterii. Pierwszą porcję moczu należy odrzucić. Nie wolno dotykać wewnętrznych części pojemnika i nakrętki.
U niemowląt i małych dzieci dopuszcza się badanie nie tylko rannej porcji. Jeśli nie możemy pobrać moczu dziecka do jałowego pojemniczka, a często jest to bardzo trudne, porcję moczu pobiera się do jałowego woreczka. Specjalne woreczki (inne dla dziewczynek i chłopców) można kupić w aptece. Dziecko należy dokładnie podmyć trzy razy wodą z mydłem, a miejsce gdzie skóra będzie stykać się z klejem osuszyć jałowym gazikiem. Po przyklejeniu woreczka, zgodnie z instrukcją na opakowaniu dobrze jest trzymać dzieciątko na rękach w pozycji pionowej, gdyż spływający do woreczka mocz nie rozleje się , a poza tym w minimalnym tylko stopniu opłukuje skórę. Można pobudzić dziecko do oddania moczu np. przez odkręcenie kranu z wodą lub przyłożyć do brzuszka mokrą, ciepłą pieluchę.Woreczek nie może być przyklejony zbyt długo , gdyż skóra może ulec odparzeniu, a ponadto do worka może dostać się zbyt dużo bakterii ze skóry. W żadnym wypadku nie wolno przyklejać woreczków na całą noc. Nie należy zbierać do woreczka kilku porcji moczu, do badania jest potrzebna tylko niewielka ilość. Pobranego moczu nie należy przelewać do pojemniczka , trzeba go zakleić i umieścić w pojemniku w pozycji pionowej tak, aby się nie wylewał.
Pobrany mocz należy dostarczyć do laboratorium w przeciągu 2 godzin, a do tego czasu przechowywać w lodówce.
Kał
Badanie kału na posiew nie wymaga od Pacjenta specjalnych przygotowań ani diety. Niewielką ilość kału (grudkę wielkości orzecha laskowego) pobraną z różnych miejsc (przede wszystkim z domieszką krwi , śluzu lub 1-2 ml przy płynnym stolcu) należy umieścić w jałowym pojemniku. Specjalne pojemniki do posiewu kału, zaopatrzone w szpatułkę dostępne są w aptekach. Należy unikać dotykania wewnętrznych powierzchni pojemnika. Pobrany materiał można przechować kilka godzin w lodówce.
- Na pobranie krwi należy zgłosić się na czczo, najlepiej rano w godzinach 6:30-12:00
- zaleca się aby wieczorem dnia poprzedzającego badanie zjeść lekkostrawną kolację
- przed pobraniem krwi pacjent powinien odpocząć przez około 10 minut
- w przypadku badań hormonów płciowych należy ustalić dzień cyklu zgodnie z zaleceniem lekarza
- w przypadku badania "krzywa cukrowa" pacjent przebywa w laboratorium 2 godziny. W tym czasie nie powinien spożywać żadnych pokarmów.
Picie i jedzenie może mechanicznie „usunąć” obecne na błonach śluzowych drobnoustroje chorobotwórcze.
Przed pobraniem wymazu należy wykonać toaletę narządów moczowo-płciowych (mycie wodą z mydłem lub płynem do higieny intymnej, ale nie bakteriobójczym). Przed planowanym badaniem nie powinno się stosować żadnych maści, globulek dopochwowych, żeli plemnikobójczych itp. Wskazane również jest zachowanie wstrzemięźliwości seksualnej na dobę przed badaniem.
Na pobranie do gabinetu ginekologicznego należy zgłosić się po przynajmniej 3 godzinnej przerwie po ostatnim oddaniu moczu , gdyż przepływający mocz może spłukać bytujące w narządach moczowo-płciowych nabłonki oraz bakterie chorobotwórcze i nie będzie możliwe ich wyhodowanie pomimo toczącej się infekcji.
Nie można dotykać wewnętrznych powierzchni pojemnika. Materiał należy dostarczyć do laboratorium w jak najkrótszym czasie.
U niemowląt i małych dzieci dopuszcza się badanie nie tylko rannej porcji. Jeśli nie możemy pobrać moczu dziecka do jałowego pojemniczka, a często jest to bardzo trudne, porcję moczu pobiera się do jałowego woreczka. Specjalne woreczki (inne dla dziewczynek i chłopców) można kupić w aptece. Dziecko należy dokładnie podmyć trzy razy wodą z mydłem, a miejsce gdzie skóra będzie stykać się z klejem osuszyć jałowym gazikiem. Po przyklejeniu woreczka, zgodnie z instrukcją na opakowaniu dobrze jest trzymać dzieciątko na rękach w pozycji pionowej, gdyż spływający do woreczka mocz nie rozleje się , a poza tym w minimalnym tylko stopniu opłukuje skórę. Można pobudzić dziecko do oddania moczu np. przez odkręcenie kranu z wodą lub przyłożyć do brzuszka mokrą, ciepłą pieluchę.Woreczek nie może być przyklejony zbyt długo , gdyż skóra może ulec odparzeniu, a ponadto do worka może dostać się zbyt dużo bakterii ze skóry. W żadnym wypadku nie wolno przyklejać woreczków na całą noc. Nie należy zbierać do woreczka kilku porcji moczu, do badania jest potrzebna tylko niewielka ilość. Pobranego moczu nie należy przelewać do pojemniczka , trzeba go zakleić i umieścić w pojemniku w pozycji pionowej tak, aby się nie wylewał.
Pobrany mocz należy dostarczyć do laboratorium w przeciągu 2 godzin, a do tego czasu przechowywać w lodówce.